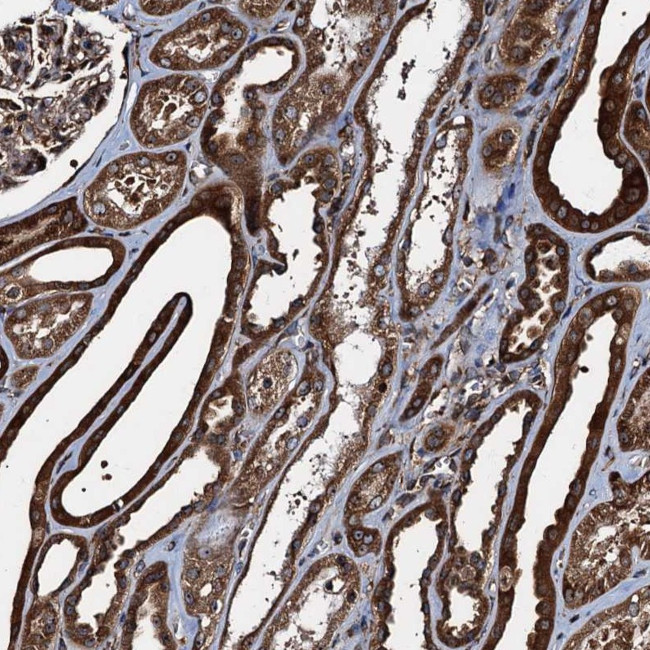
ATP2C1 Antibody in Immunohistochemistry (Paraffin) (IHC (P))

Search
Invitrogen
ATP2C1 Polyclonal Antibody
{{$productOrderCtrl.translations['antibody.pdp.commerceCard.promotion.promotions']}}
{{$productOrderCtrl.translations['antibody.pdp.commerceCard.promotion.viewpromo']}}
{{$productOrderCtrl.translations['antibody.pdp.commerceCard.promotion.promocode']}}: {{promo.promoCode}} {{promo.promoTitle}} {{promo.promoDescription}}. {{$productOrderCtrl.translations['antibody.pdp.commerceCard.promotion.learnmore']}}
产品信息
PA5-111052
种属反应
宿主/亚型
分类
类型
抗原
偶联物
形式
浓度
规格
纯化类型
保存液
内含物
保存条件
运输条件
RRID
产品详细信息
Immunogen sequence: AIASRLGLYS KTSQSVSGEE IDAMDVQQLS QIVPKVAVFY RASPRHKMKI IKSLQKNGSV VAMTGD
Highest antigen sequence indentity to the following orthologs: Rat - 94%, Mouse - 92%.
靶标信息
ATP2C1, also known as secretory pathway Ca2+/Mn2+-ATPase (SPCA) 1, belongs to the family of P-type cation transport ATPases. This magnesium-dependent enzyme catalyzes the hydrolysis of ATP coupled with the transport of the calcium from the cytosol to the Golgi lumen. Defects in this gene cause Hailey-Hailey disease, an autosomal dominant disorder characterized by persistent blisters and erosions of the skin. Unlike the related protein ATP2C2, ATP2C1 is ubiquitously expressed and displays a lower maximal turnover rate for overall Ca2+-ATPase reaction and a higher apparent affinity for cytosolic Ca2+ activation of phosphorylation. Recent evidence suggests that ATP2C1 is a key regulator of insulin-like growth factor receptor (IGF1R) processing in tumor progression in basal breast cancers.
仅用于科研。不用于诊断过程。未经明确授权不得转售。
篇参考文献 (0)
生物信息学
蛋白别名: ATP-dependent Ca(2+) pump PMR1; ATPase 2C1; ATPase, Ca(2+)-sequestering; ATPase, Ca++ transporting, type 2C, member 1; Ca(2+)/Mn(2+)-ATPase 2C1; Calcium-transporting ATPase type 2C member 1; calcium-transporting ATPase type 2C member 1 M; calcium-transporting ATPase type 2C member 1 MU; HUSSY 28; HUSSY-28; rat; Secretory pathway Ca(2+)-transporting ATPase type 1; secretory pathway Ca2+/Mn2+ ATPase 1; SPCA1; SPCA1; ATP2C1b; SPCA1d; ATP2C1d; unnamed protein product
基因别名: ATP2C1; ATP2C1A; BCPM; HHD; hSPCA1; HUSSY-28; KIAA1347; PMR1; PMR1L; SPCA1
UniProt ID: (Human) P98194
Entrez Gene ID: (Human) 27032